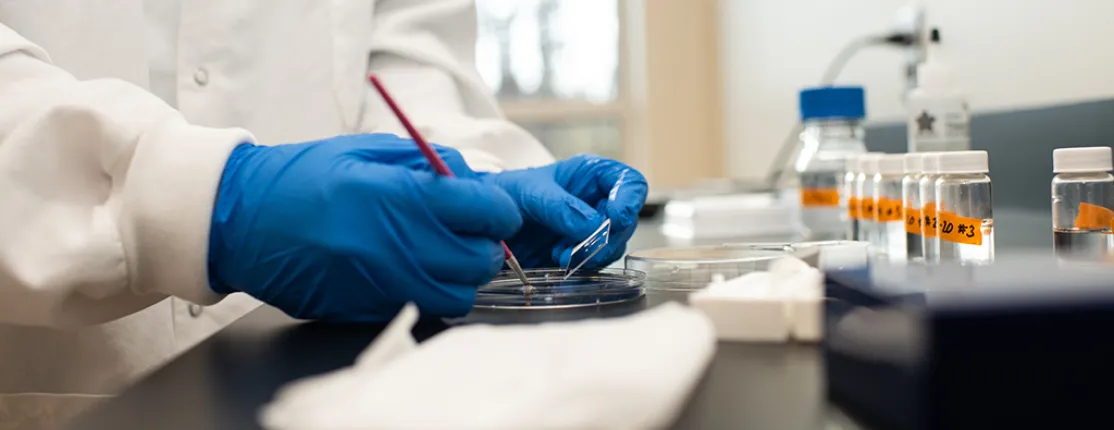
A close-up of hands in blue latex gloves working on a petri dish

Graduate School of Biomedical Science and Engineering
The Graduate School of Biomedical Science and Engineering (GSBSE) is a unique University of Maine graduate program in collaboration with other research and academic institutions in Maine including the Jackson Laboratory, the Maine Medical Center Research Institute at the Mount Desert Island Biological Laboratory, and the University of New England.
Students from across the nation and the globe are attracted to the innovative programs offered by GSBSE, including the Ph.D. in Biomedical Science and the Ph.D. in Biomedical Engineering. From the GSBSE program, students gain invaluable knowledge and experience through cutting-edge research guided by renowned faculty in first-rate facilities.
Research focus areas include Molecular and Cellular Biology, Bioinformatics and Genomics, Toxicology, Neuroscience, and Biomedical Engineering.
View faculty, students, and alumni affiliated with GSBSE at UNE
See the GSBSE Faculty and Ph.D. Student Handbook (PDF) for program details.